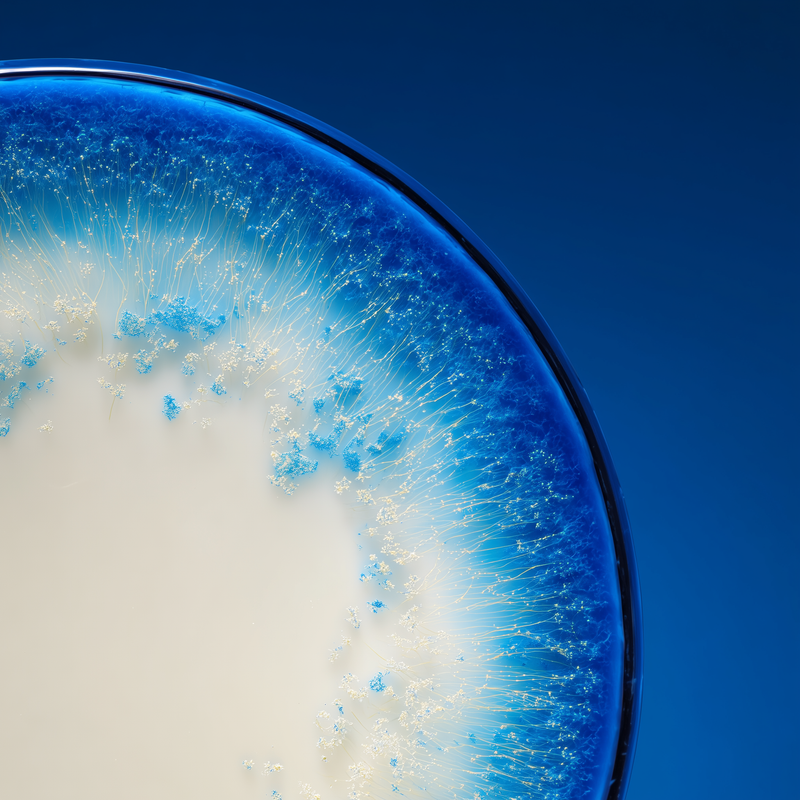

Primeras 4 semanas
Durante el primer mes, el organismo puede comenzar a mostrar cambios en la regulación del apetito y estabilización glucémica, sentando las bases para la reducción gradual del peso corporal.
- Puedes experimentar mejor control sobre porciones alimentarias
- Puede contribuir a la reducción de antojos que sabotean el peso
- Ayuda a favorecer mayor estabilidad en los niveles de energía

3 MESES
Con 12 semanas de uso continuado, el organismo puede mostrar cambios evidentes en peso corporal, composición corporal y perímetro abdominal como resultado del reequilibrio integral.
- Puede contribuir a la reducción del peso corporal hasta 1.8kg*
- Ayuda a la disminución del perímetro de cintura hasta 2.3cm*
- Contribuye a la mejora del índice de masa corporal*
- Favorece el mantenimiento del peso conseguido naturalmente
Frontiers in Nutrition 2023
Efectos del Probiótico L. plantarum IMC 510® en Peso Corporal y Microbiota

DE 3 A 6 MESES
Con el uso continuado más allá de 3 meses, el organismo puede consolidar los cambios logrados, optimizando el reequilibrio de la microbiota y favoreciendo el mantenimiento sostenible del peso sin efecto rebote.
- Puede contribuir al mantenimiento estable del peso conseguido
- Ayuda a la consolidación de hábitos alimentarios más equilibrados
- Contribuye al reequilibrio duradero de la microbiota intestinal
- Favorece la flexibilidad metabólica y prevención del efecto rebote
La Ciencia Detrás de SACIADA
1. PESO
L. plantarum IMC 510® puede contribuir a la reducción del peso corporal y perímetro de cintura mediante modulación de la microbiota intestinal, mientras que el complejo termogénico suave apoya el metabolismo energético natural para favorecer el equilibrio del peso
2. SACIEDAD
El mango africano puede contribuir a apoyar el equilibrio natural de leptina y adiponectina, mientras que la regulación del apetito favorece naturalmente un balance calórico que puede contribuir al control del peso

3. GLUCOSA
Reducose® puede contribuir a la reducción de picos glucémicos hasta un 24%, favoreciendo una respuesta insulínica más controlada que puede ayudar a prevenir el almacenamiento excesivo de grasa
4. MICROBIOTA
L. plantarum IMC 510® puede contribuir a la reducción del ratio F/B, el aumento de bacterias beneficiosas como Lactobacillus y Bifidobacterium, favoreciendo un perfil microbiano más asociado con peso corporal saludable
1. PESO
L. plantarum IMC 510® puede contribuir a la reducción del peso corporal y perímetro de cintura mediante modulación de la microbiota intestinal, mientras que el complejo termogénico suave apoya el metabolismo energético natural para favorecer el equilibrio del peso
2. SACIEDAD
El mango africano puede contribuir a apoyar el equilibrio natural de leptina y adiponectina, mientras que la regulación del apetito favorece naturalmente un balance calórico que puede contribuir al control del peso

3. GLUCOSA
Reducose® puede contribuir a la reducción de picos glucémicos hasta un 24%, favoreciendo una respuesta insulínica más controlada que puede ayudar a prevenir el almacenamiento excesivo de grasa
4. MICROBIOTA
L. plantarum IMC 510® puede contribuir a la reducción del ratio F/B, el aumento de bacterias beneficiosas como Lactobacillus y Bifidobacterium, favoreciendo un perfil microbiano más asociado con peso corporal saludable
- Personas que buscan un enfoque integral para la reducción de peso corporal, especialmente aquellos que han experimentado dificultades con métodos restrictivos o han notado efecto rebote con dietas extremas.
- Personas que desean abordar múltiples factores que dificultan el control del peso simultáneamente: metabolismo lento, antojos intensos, grasa abdominal persistente y desequilibrio de la microbiota, como parte de un plan integral de salud.
- Mujeres y hombres que prefieren soluciones basadas en evidencia científica sólida y buscan ingredientes con estudios clínicos específicos en humanos para la reducción del peso corporal y la modulación de la composición corporal.
- Personas que experimentan fluctuaciones de peso relacionadas con estrés, cambios hormonales o alteraciones de la microbiota, y buscan un reequilibrio natural que favorezca la pérdida de peso sostenible.
- Personas que valoran un enfoque no restrictivo para el manejo del peso, priorizando la mejora de la regulación natural del organismo y la optimización metabólica sobre métodos agresivos o insostenibles.
- Tomar 1 cápsula al día con un vaso grande de agua, preferiblemente 30 minutos antes de la comida principal.
- Para resultados óptimos en el control del peso, mantener uso continuado durante al menos 12 semanas junto con alimentación equilibrada y actividad física regular según tolerancia individual.
Actúa sobre el eje intestino-cerebro mediante ingredientes clínicamente estudiados que pueden modular el peso corporal a través de múltiples vías: estabilización de la respuesta glucémica, optimización de hormonas de saciedad como leptina, reequilibrio de la microbiota y activación suave del metabolismo. L. plantarum IMC 510® contribuye específicamente a la reducción del peso mediante modulación de la microbiota, mientras que Reducose® ayuda a prevenir el almacenamiento de grasa al controlar picos glucémicos.
No hay resultados

¿NECESITO TOMARLO DE FORMA CONTINUA?
Sí, para obtener resultados sostenidos. Nuestros nutricosméticos están formulados para trabajar progresivamente. Recomendamos un mínimo de 6 meses de uso continuado para transformar la piel de forma profunda y estable.
¿PUEDO TOMARLA SI ESTOY EMBARAZADA O EN PERÍODO DE LACTANCIA?
Siempre consultar primero con tu médico antes de tomar cualquier suplemento (incluidos los nuestros). Aunque nuestros nutricosméticos están formulados con activos naturales y seguros en condiciones normales, durante el embarazo y la lactancia las necesidades y sensibilidades del cuerpo cambian.
La seguridad de tu bebé y tu bienestar son lo primero.
Si estás en estas etapas tan especiales, te animamos a hablarlo con tu profesional de confianza para valorar lo mejor para ti.
¿HAY EFECTO REBOTE SI DEJO DE TOMARLA?
No, no existe efecto rebote. Simplemente, el cuerpo volverá poco a poco a su punto de partida.
La clave está en la continuidad.
INDREDIENTES
Activos
| Ingrediente | Dosis | VRN |
|---|---|---|
| Reducose® (Morus Alba) | 250 mg | |
| Extracto Seco de Semilla de Mango Africano (Irvingia Gabonensis) | 50 mg | |
| Extracto Seco de Hoja de Té Verde (Camellia Sinensis L,) | 50 mg | |
| Lactobacillus Plantarum Imc 510 | 1 × 10¹⁰ UFC | |
| Vitamina B6 (Clorhidrato de Piridoxina) | 3,03 mg | 216,14% |
| Picolinato de Cromo | 250 μg | 625% |























